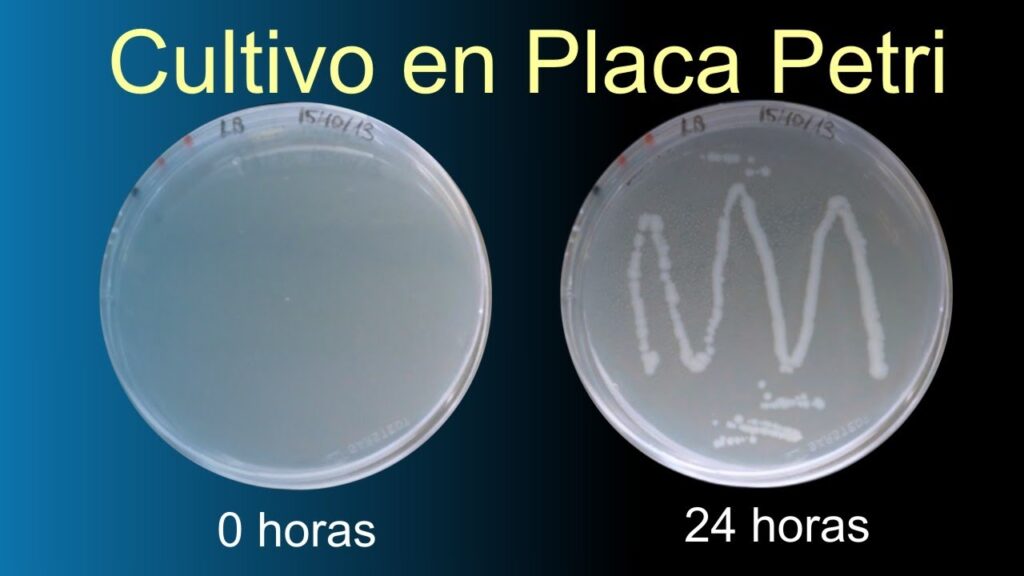

Sembrar en cajas Petri es una técnica muy utilizada en microbiología y biotecnología para cultivar microorganismos y estudiar su crecimiento y desarrollo. Las cajas Petri son recipientes de vidrio o plástico en forma de plato con una tapa que se utiliza para contener medios de cultivo y muestras biológicas. En este proceso, se colocan pequeñas cantidades de muestras biológicas en los medios de cultivo y se incuban a una temperatura y condiciones adecuadas para el crecimiento de los microorganismos. En esta guía, te mostraremos los pasos para sembrar en cajas Petri de manera efectiva y obtener resultados precisos en tus experimentos.
Cómo sembrar en una caja Petri: Guía paso a paso para cultivar microorganismos en casa
Las cajas Petri son recipientes de plástico que se utilizan en laboratorios para cultivar microorganismos. Si estás interesado en la microbiología y te gustaría cultivar tus propios microorganismos en casa, sembrar en una caja Petri es una excelente opción. En esta guía paso a paso, te explicaremos cómo sembrar en una caja Petri para cultivar microorganismos en casa.
Paso 1: Preparación
Antes de comenzar, es importante que tengas todo el material necesario a mano. Necesitarás:
- Cajas Petri estériles
- Medio de cultivo
- Agar
- Inoculador
- Alcohol
- Fuego
- Microorganismos para sembrar
Es importante que trabajes en un ambiente limpio y estéril, así que asegúrate de lavarte bien las manos y desinfectar el área de trabajo antes de comenzar.
Paso 2: Preparar el medio de cultivo
El medio de cultivo es el sustrato donde crecerán tus microorganismos. Para preparar el medio de cultivo, sigue las instrucciones del paquete. Por lo general, deberás calentar el medio de cultivo en una olla hasta que se disuelva por completo. Luego, agrega agar al medio de cultivo y revuelve bien hasta que se disuelva también.
Paso 3: Verter el medio de cultivo en la caja Petri
Una vez que hayas preparado el medio de cultivo con agar, deberás verterlo en la caja Petri. Asegúrate de que la caja Petri esté estéril antes de verter el medio de cultivo. Para esterilizarla, puedes pasarla por una llama o sumergirla en alcohol. Una vez que la caja Petri esté estéril, vierte el medio de cultivo en la caja hasta que cubra aproximadamente la mitad de la superficie de la caja.
Paso 4: Inocular los microorganismos
Una vez que hayas vertido el medio de cultivo en la caja Petri, deberás esperar a que se solidifique. Una vez que el medio de cultivo esté sólido, estarás listo para sembrar los microorganismos. Utiliza un inoculador para transferir los microorganismos a la caja Petri. Asegúrate de que el inoculador esté estéril antes de usarlo. Para esterilizar el inoculador, puedes sumergirlo en alcohol y pasarlo por una llama.
Paso 5: Incubar la caja Petri
Una vez que hayas sembrado los microorganismos en la caja Petri, deberás incubar la caja en un ambiente cálido y oscuro para que los microorganismos puedan crecer. La temperatura ideal para incubar la caja Petri es de 37 grados Celsius. Deberás dejar la caja Petri incubando durante unos días, dependiendo del tipo de microorganismo que hayas sembrado.
Paso 6: Observar los resultados
Una vez que hayas incubado la caja Petri durante el tiempo necesario, estarás listo para observar los resultados. Abre la caja Petri y observa los microorganismos que hayan crecido. Toma nota de las características de los microorganismos, como su forma, color y textura.
Sembrar en una caja Petri es una excelente manera de cultivar tus propios microorganismos en casa. Sigue esta guía paso a paso para sembrar en una caja Petri y comienza a explorar el mundo de la microbiología desde la comodidad de tu hogar.
Guía completa para preparar medios de cultivo en caja Petri: paso a paso y consejos útiles
Las cajas Petri son recipientes planos y redondos que se utilizan para cultivar microorganismos. Para sembrar en cajas Petri, es necesario preparar el medio de cultivo adecuado. A continuación, se presenta una guía completa para preparar medios de cultivo en caja Petri:
- Seleccionar el medio de cultivo: El medio de cultivo debe ser seleccionado según el tipo de microorganismo que se desee cultivar. Hay diferentes tipos de medios de cultivo, tales como los medios de agar nutritivo, los medios de agar MacConkey, entre otros.
- Preparar el medio de cultivo: El medio de cultivo debe ser preparado siguiendo las instrucciones del fabricante o utilizando una fórmula específica. Es importante esterilizar el medio de cultivo antes de utilizarlo para evitar la contaminación del cultivo.
- Verter el medio de cultivo en la caja Petri: Después de preparar el medio de cultivo, se debe verter en la caja Petri estéril. Para hacerlo, se puede utilizar una pipeta o una varilla de vidrio estéril. Es importante llenar la caja Petri hasta aproximadamente la mitad, para evitar que el medio de cultivo se derrame al momento de inclinar la caja.
- Dejar solidificar el medio de cultivo: Una vez que el medio de cultivo ha sido vertido en la caja Petri, se debe dejar solidificar. Esto se logra al dejar la caja Petri tapada en posición horizontal durante un tiempo determinado, dependiendo del tipo de medio de cultivo utilizado.
- Sembrar el cultivo: Una vez que el medio de cultivo ha solidificado, se puede sembrar el cultivo. Para hacerlo, se utiliza una asa de siembra estéril para tomar una muestra del cultivo y se deposita en el centro de la caja Petri. Es importante evitar tocar los bordes de la caja con el asa de siembra, para evitar la contaminación del cultivo.
- Incubar la caja Petri: Después de sembrar el cultivo, se debe incubar la caja Petri en un ambiente adecuado para el crecimiento del microorganismo. El tiempo y la temperatura de incubación varían según el tipo de microorganismo y el medio de cultivo utilizado.
Siguiendo estos pasos, se puede sembrar en cajas Petri de manera efectiva. Es importante recordar mantener la técnica aséptica en todo momento para evitar la contaminación del cultivo. Además, es útil etiquetar la caja Petri con información relevante, como el tipo de medio de cultivo utilizado y la fecha de siembra.
Guía completa de uso de la caja de Petri: pasos y consejos prácticos
La caja de Petri es un elemento clave en el mundo de la microbiología, ya que permite la observación y cultivo de microorganismos en un ambiente controlado. A continuación, te presentamos una guía completa de uso de la caja de Petri, con todos los pasos necesarios para sembrar en ella de forma adecuada.
Paso 1: Preparación del medio de cultivo
Lo primero que debemos hacer es preparar el medio de cultivo que vamos a utilizar. Este medio debe ser específico para el tipo de microorganismo que queremos cultivar, y debe estar esterilizado para evitar la contaminación del cultivo.
Para preparar el medio de cultivo, debemos seguir las instrucciones del fabricante y esterilizarlo en un autoclave o utilizando filtros esterilizantes. Una vez que el medio esté esterilizado, lo vertemos en la caja de Petri, dejando una capa uniforme en el fondo.
Paso 2: Siembra del microorganismo
Una vez que tenemos el medio de cultivo en la caja de Petri, podemos sembrar el microorganismo que queremos cultivar. Para ello, debemos tomar una muestra del microorganismo y depositarla en el centro de la caja de Petri, utilizando una pipeta esterilizada.
Es importante que la muestra sea lo más homogénea posible, para evitar que se formen colonias aisladas que dificulten su observación. También es importante que la cantidad de muestra que sembremos sea la adecuada, para evitar una sobrecarga del medio de cultivo.
Paso 3: Incubación
Una vez que hemos sembrado el microorganismo en la caja de Petri, debemos incubarla en condiciones adecuadas para su crecimiento. La temperatura, humedad y tiempo de incubación dependerán del tipo de microorganismo que estemos cultivando, y debemos seguir las instrucciones específicas para cada caso.
Es importante que la caja de Petri esté cerrada durante la incubación, para evitar la contaminación del cultivo con microorganismos del ambiente.
Paso 4: Observación
Una vez que el microorganismo ha crecido en la caja de Petri, podemos observarlo y analizarlo. Para ello, podemos utilizar técnicas de microscopía o análisis bioquímicos que nos permitan identificar el tipo de microorganismo que hemos cultivado.
Es importante que sigamos las normas de seguridad e higiene durante todo el proceso, utilizando guantes, batas y gafas de protección para evitar la contaminación del cultivo y proteger nuestra salud.
Con estos pasos y consejos prácticos, podrás utilizar la caja de Petri de forma adecuada y obtener resultados precisos en tus cultivos microbiológicos.
Técnicas efectivas de sembrado bacteriano: Guía completa y paso a paso
El sembrado bacteriano en cajas Petri es una técnica fundamental en microbiología para la identificación y estudio de bacterias. En este artículo, te enseñaremos técnicas efectivas de sembrado bacteriano en cajas Petri, paso a paso.
Paso 1: Preparar el medio de cultivo
Primero, prepara el medio de cultivo adecuado según la bacteria que deseas estudiar. Asegúrate de seguir las instrucciones de preparación del medio y esteriliza el medio en autoclave o mediante filtración.
Paso 2: Preparar las cajas Petri
Una vez que el medio de cultivo esté listo, prepara las cajas Petri esterilizándolas en autoclave o en una llama abierta. Es importante trabajar en un ambiente estéril para evitar la contaminación del medio.
Paso 3: Inoculación de las bacterias
Para la inoculación de las bacterias, utiliza una pipeta estéril y coloca una pequeña cantidad de la muestra bacteriana en el centro de la caja Petri. Puedes utilizar diferentes técnicas de inoculación, como la técnica de siembra en zigzag o la técnica de siembra en estrías.
Paso 4: Incubación
Una vez que hayas inoculado las bacterias en el medio de cultivo, asegúrate de colocar las cajas Petri en una incubadora a la temperatura adecuada para el crecimiento de la bacteria. El tiempo de incubación puede variar dependiendo de la bacteria que estés cultivando.
Paso 5: Observación de las colonias bacterianas
Una vez que las bacterias hayan crecido en las cajas Petri, observa las colonias bacterianas al microscopio y realiza pruebas para identificar la especie bacteriana.
Sigue estos pasos efectivos para sembrar bacterias en cajas Petri y asegúrate de trabajar en un ambiente estéril para evitar la contaminación del medio. ¡Buena suerte en tus experimentos!
En conclusión, sembrar en cajas Petri es una técnica útil y sencilla que puede ser utilizada en diversos campos, desde la microbiología hasta la agricultura. Con los pasos adecuados y la atención necesaria, es posible obtener resultados precisos y de calidad en los experimentos y cosechas. Es importante seguir las medidas de seguridad y esterilización para evitar contaminaciones y asegurar los mejores resultados. Esperamos que esta guía haya sido útil y puedan ponerla en práctica en sus proyectos y cultivos.